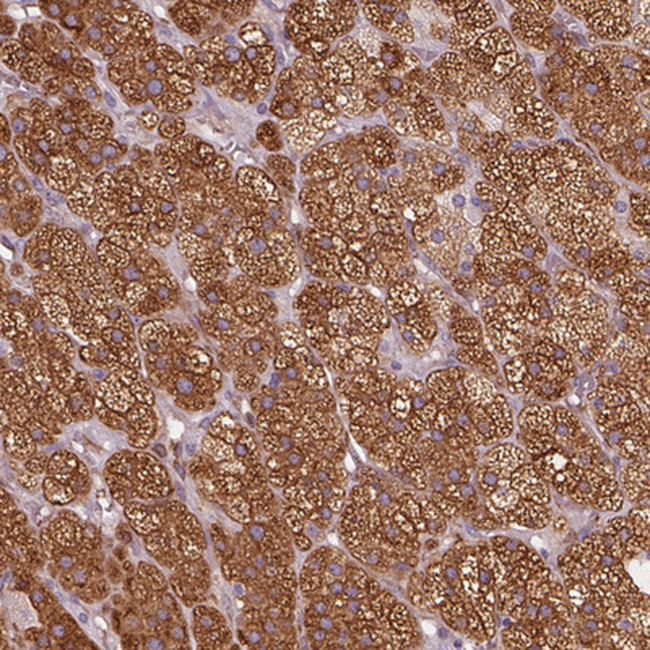
HSD3B1 Antibody in Immunohistochemistry (Paraffin) (IHC (P))

Search
Invitrogen
HSD3B1 Polyclonal Antibody
{{$productOrderCtrl.translations['antibody.pdp.commerceCard.promotion.promotions']}}
{{$productOrderCtrl.translations['antibody.pdp.commerceCard.promotion.viewpromo']}}
{{$productOrderCtrl.translations['antibody.pdp.commerceCard.promotion.promocode']}}: {{promo.promoCode}} {{promo.promoTitle}} {{promo.promoDescription}}. {{$productOrderCtrl.translations['antibody.pdp.commerceCard.promotion.learnmore']}}
产品信息
PA5-111193
种属反应
宿主/亚型
分类
类型
抗原
偶联物
形式
浓度
规格
纯化类型
保存液
内含物
保存条件
运输条件
RRID
产品详细信息
Immunogen sequence: ESIMNVNVKG TQLLLEACVQ ASVPVFIYTS SIEVAGPNSY KEIIQNGHEE EPLE
Highest antigen sequence indentity to the following orthologs: Mouse - 72%, Rat - 70%.
靶标信息
Amyloid beta peptide (Abeta/Beta-amyloid) is the major constituent of amyloid plaques in the brains of individuals afflicted with Alzheimer's disease. Abeta peptide is 40-43 amino acids long and generated from the beta-amyloid precursor protein (beta APP) in a two-step process. The first step involves cleavage of the extracellular, amino-terminal domain of beta APP. Protein cleavage is performed by an aspartyl protease, beta-secretase (BACE) which is synthesized as a propeptide and must be modified to the mature and active form by the prohormone convertase, furin. Beta APP cleavage by the mature form of BACE results in the cellular secretion of a segment of beta APP, and a membrane-bound remnant. The remnant protein is processed by another protease, gamma-secretase. Gamma-secretase cleaves an intra-membrane site in the carboxyl-terminal domain of beta APP, thus generating the amyloid beta peptide. Gamma-secretase is believed to be a multi-subunit complex containing presenilin-1 and 2 as central components. The transmembrane glycoprotein, nicastrin, is associated with presinilins and has been found to bind to the carboxyl-terminus of beta APP and helps to modulate the production of the amyloid beta peptide. Abeta is an extracellular filamentous protein component of amyloid cores, neuritic plaques and is also found as a deposit in neurofibrillary tangles. Alzheimer's disease, the most common cause of senile dementia, is characterized by abnormal filamentous protein deposits in the brain. Beta amyloid deposits are also detected in Lewy body dementia, Down's syndrome, amyloidosis (Dutch type), cerebroarterial amyloidosis (cerebral amyloid angiopathy) and in the Guam Parkinson-Dementia complex.
仅用于科研。不用于诊断过程。未经明确授权不得转售。
篇参考文献 (0)
生物信息学
蛋白别名: 3 beta-hydroxy-5-ene steroid dehydrogenase; 3 beta-hydroxysteroid dehydrogenase/Delta 5-->4-isomerase type 1; 3 beta-hydroxysteroid dehydrogenase/Delta 5-->4-isomerase type I; 3-beta-HSD I; 3-beta-hydroxy-5-ene steroid dehydrogenase; 3-beta-hydroxy-Delta(5)-steroid dehydrogenase; 3-beta-hydroxysteroid 3-dehydrogenase; 3-beta-hydroxysteroid dehydrogenase/5-4-isomerase; Delta-5-3-ketosteroid isomerase; Dihydrotestosterone oxidoreductase; HGNC:5217; progesterone reductase; short chain dehydrogenase/reductase family 11E, member 1; Steroid Delta-isomerase; Trophoblast antigen FDO161G; unnamed protein product
基因别名: 3BETAHSD; 3BH; HSD3B; HSD3B1; HSDB3; HSDB3A; SDR11E1
UniProt ID: (Human) P14060
Entrez Gene ID: (Human) 3283